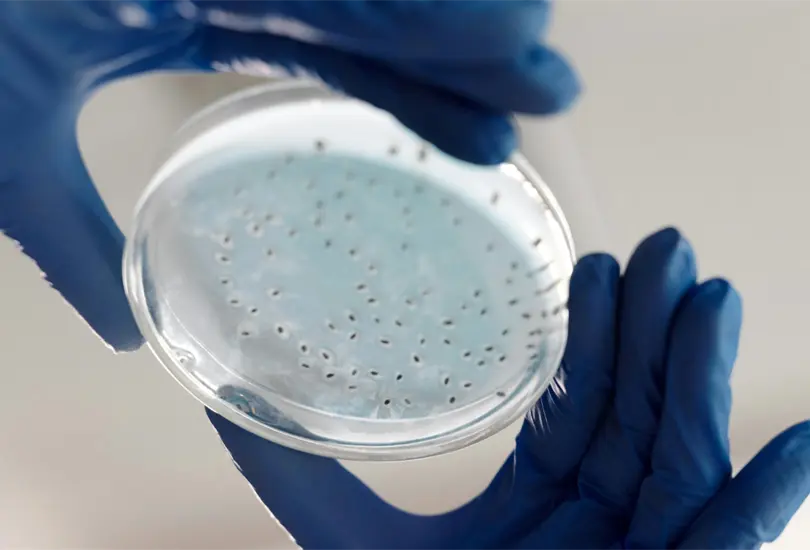
Foto ilustrativa

- 11 de abril de 2026
Un brote de la bacteria Klebsiella oxytoca ha puesto en alerta a los hospitales del Estado de México
Un brote de Klebsiella oxytoca encendió las alarmas en el Estado de México, tras afectar a 15 pacientes hospitalizados en cuatro unidades médicas.
La bacteria, conocida por causar infecciones graves en entornos hospitalarios, fue detectada en casos vinculados a la nutrición parenteral total (NPT), un procedimiento vital para pacientes que no pueden ingerir alimentos por vías convencionales. Ante esta situación, la Secretaría de Salud emitió una alerta epidemiológica y reforzó las medidas de vigilancia en los hospitales afectados.

¿Qué es la Klebsiella oxytoca?
La Klebsiella oxytoca pertenece al grupo de bacterias gramnegativas, que suelen habitar de manera inofensiva en el tracto intestinal. Sin embargo, en condiciones específicas, como sistemas inmunitarios debilitados o procedimientos médicos invasivos, se convierten en patógenos oportunistas capaces de provocar infecciones graves. Este microorganismo es especialmente peligroso en entornos hospitalarios, donde puede propagarse rápidamente y causar complicaciones potencialmente mortales.
El brote actual está relacionado con la posible contaminación en la cadena de suministro de productos utilizados en la nutrición parenteral total (NPT). Este método de alimentación intravenosa es esencial para pacientes que no pueden comer por vía oral, pero requiere de manipulación extremadamente cuidadosa para evitar infecciones.

La contaminación pudo ocurrir durante la preparación, almacenamiento o administración de las soluciones. Las autoridades investigan cómo la bacteria logró introducirse en este proceso, mientras intensifican las inspecciones en las cadenas de suministro.
Síntomas y riesgos
Las infecciones por Klebsiella oxytoca pueden presentarse de diferentes maneras, dependiendo del sistema afectado. En el caso del brote en el Edomex, que involucra infecciones en el torrente sanguíneo, los síntomas más comunes incluyen:
- Fiebre alta y escalofríos.
- Taquicardia.
- Dificultad para respirar.
- Alteraciones en el estado mental, como confusión.
- Signos de sepsis, una respuesta inflamatoria grave que puede derivar en insuficiencia multiorgánica.
- Sin tratamiento oportuno, estas infecciones pueden ser mortales, especialmente en pacientes vulnerables.
¿Quiénes corren mayor riesgo?
Esta bacteria afecta principalmente a personas hospitalizadas, especialmente aquellas en estado crítico o con dispositivos médicos invasivos, como catéteres o ventiladores mecánicos. Además, los recién nacidos, los adultos mayores y las personas inmunodeprimidas son particularmente susceptibles. El uso de antibóticos de amplio espectro también puede alterar el equilibrio bacteriano del cuerpo, aumentando el riesgo de infección.
La Secretaría de Salud ha implementado medidas de contención para evitar la propagación de la bacteria, entre ellas:
- Refuerzo de las prácticas de higiene y control de calidad en hospitales.
- Monitoreo estricto de los pacientes en riesgo.
- Inspecciones detalladas en las cadenas de suministro de productos médicos.
Estos esfuerzos buscan contener el brote y prevenir futuros casos, mientras se investigan las posibles fallas en los procedimientos hospitalarios.
Síguenos en WHATSAPP y suscríbete a nuestro NEWSLETTER para continuar siempre informado.
Para más noticias, no dudes en seguirnos en Google News y en nuestro canal de WhatsApp para recibir la mejor información. Te invitamos a suscribirte gratis a nuestro Newsletter.






